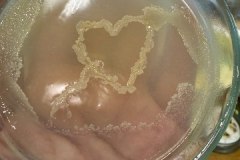
5f084cf0-8ec1-4eae-a8a7-11fc76af05d2
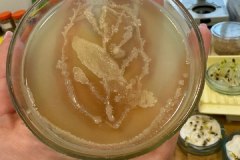
936068b6-ff0e-4f52-815e-8ec83b5932cd

У Поліському університеті провели засідання студентського Мікробіологічного гуртка
На кафедрі здоров᾽я фітоценозів і трофології агрономічного факультету Поліського національного університету 11 грудня відбулося засідання студентського Мікробіологічного гуртка «Мікробіологічні добрива та біопрепарати в захисті рослин», на якому були висвітлені питання здоров’я рослин і довкілля в контексті застосування мікробіологічних добрив та біопрепаратів в захисті рослин від шкідливих організмів.
Спікер заходу – Ірина Іващенко, к.б.н., доцент кафедри здоров’я фітоценозів і трофології, керівник Мікробіологічного гуртка.
Із змістовними, пізнавальними доповідями виступили здобувачі вищої освіти ОП «Захист і карантин рослин» першого (бакалаврського) і другого (магістерського) рівнів вищої освіти. На засіданні Мікробіологічного гуртка були присутні також викладачі кафедри здоров’я фітоценозів і трофології.
Учасники заходу продемонстрували також присутнім мікробіологічні візерунки, які намалювали живими мікроорганізмами на поживних середовищах за допомогою бактеріальної петлі.
Робота наукового Мікробіологічного гуртка спрямована на залучення студентів до самостійної науково-дослідницької діяльності з питань екологічно безпечного захисту рослин.
Пресслужба Поліського національного університету